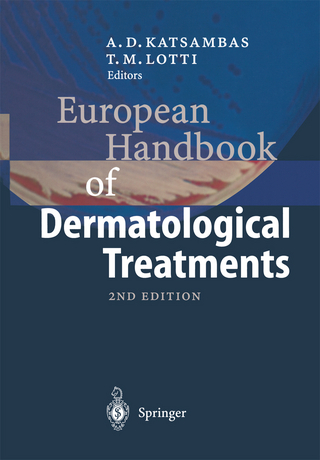
European Handbook of Dermatological Treatments

Buch | Hardcover
2020
|
Springer Verlag, Singapore
ISBN: 9789811565595
CHF 369,95 (inkl. MwSt)
- Versand in
15-20 Tagen